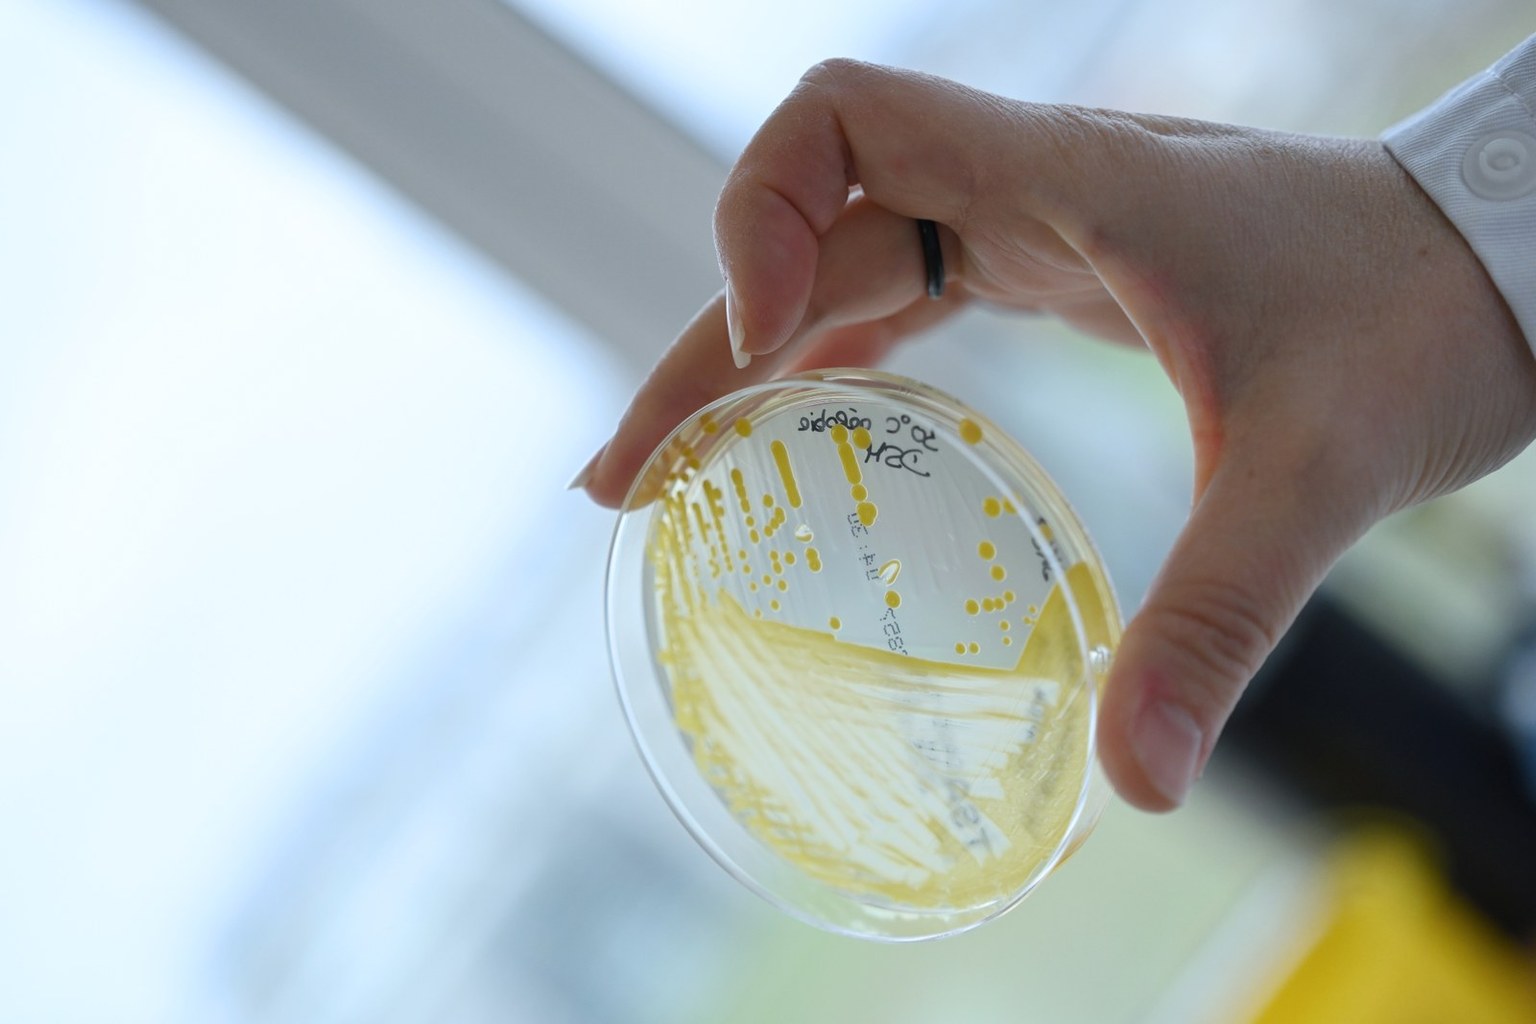

Maintenance and preservation of microbial cultures
We safeguard your microbiological samples for years in dedicated storage infrastructures. Each sample is clearly labelled, digitally registered and stored in cryotubes at −80 °C. Freezers are backed by an uninterruptible power supply and located in controlled-access areas.
Temperatures are continuously monitored with alarm systems for any deviation. Together with our ISO 9001 quality system, this ensures the integrity, compliance and full traceability of your collections.
High-quality biobanking management: our strong microbiology expertise
By working with Smaltis, you benefit from a biobanking service embedded in a microbiology center of excellence.
Our experienced microbiologists can process your samples on demand, from culture revival and purity checks, to identification and characterization.
By combining secure storage with expert microbiology, your strains become valuable assets that can be mobilized for quality controls or research projects.
We design with you the most relevant analyses or studies and ensure fast, reliable handling and return of your materials whenever you need them.

Your private off-site microbial deposit & storage
Your microbial resources are deposited, managed and exploited from a single site, operated by a trusted independent laboratory.
Located in Besançon, in the heart of Europe, Smaltis acts as a central laboratory hub for your European logistics.
We coordinate shipments and returns with your various sites and partners to simplify flows and secure timelines.
Our customers include pharma players for human and veterinay health, nutrition and food, dermatology, environment and public research infrastructures.

 Back to homepage
Back to homepage






